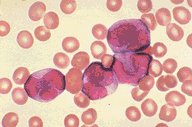

Description
This peripheral blood smear, at low oil magnification, is of a Wright's
stained specimen in a patient with ANLL M3, microgranular. Many
of the nuclei could be confused with abnormal monocytes.
|
|
Click on this image
to enlarge it, then
on Back buttom
in the Netscape Menu
to shrink it back down



|